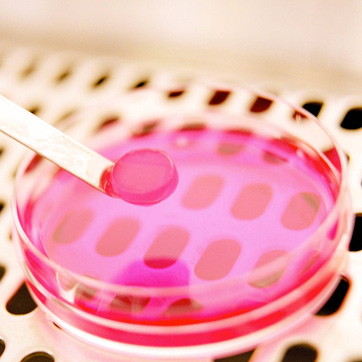

Cellule staminali pluripotenti da pelle e urina
Nasce a Padova una rivoluzionaria tecnologia che permette di ottenere cellule staminali pluripotenti da una biopsia cutanea o da un campione di urina mediante il processo di riprogrammazione cellulare. Questa innovativa tecnologia microfluidica ha dimostrato un’efficienza elevatissima, oltre 50 volte più efficiente dei processi ad oggi in uso, e consente di abbattere i costi di oltre 100 volte, di riprogrammare anche cellule “difficili o senescenti” da riprogrammare e, in sostanza, estende ad ogni paziente la possibilità di ottenere le proprie cellule staminali.
“Grazie a queste nuove prospettive scientifiche e tecnologiche, si è riusciti ad ottenere cellule staminali pluripotenti da cellule isolate da una biopsia cutanea o da un campione di urina. Cellule derivate da un campione di urina hanno permesso di ottenere in modo non invasivo ed estremamente semplice cellule staminali pluripotenti da bambini affetti da malattie genetiche come la distrofia muscolare di Duchenne o la deficienza di alfa-1 antitripsina – spiega Nicola Elvassore, responsabile scientifico del laboratorio BioERA e coordinatore dello studio – Grazie alla potenzialità delle cellule staminali pluripotenti, abbiamo ricreato in laboratorio quello che possiamo definire un “micro-fegato”, ovvero cellule del fegato che presentano la medesima patologia del paziente in esame e che ci permette di andare a sviluppare una terapia mirata sul paziente stesso”.
Lo studio, condotto da ricercatori del dipartimento di Ingegneria industriale dell’università di Padova e dell’Istituto Veneto di Medicina Molecolare (VIMM), è stato pubblicato recentemente nella rivista Nature Methods.
"La tecnologia sviluppata nel laboratorio BioERA si basa sull’impiego di chip microfluidici prodotti utilizzando tecniche litografiche simili a quelle usate in microelettronica – spiega Nicola Elvassore – L'impiego di sistemi miniaturizzati per applicazioni cellulari non rappresenta solo una riduzione di scala, ma perturba la biologia delle cellule staminali, ampliando la nostra possibilità di controllo del comportamento cellulare”.
Le ricerche, durate quasi 5 anni, hanno dimostrato come proprio le ridotte dimensioni del sistema siano responsabili del notevole incremento di efficienza del processo di riprogrammazione cellulare. Una delle conseguenze più importanti di questa scoperta è la possibilità di derivare cellule staminali pluripotenti da pazienti su larga scala, da impiegare poi nella produzione di tessuti umani in vitro per testare farmaci in laboratorio a basso costo e in tempi rapidi.
Le differenze intrinseche presenti da individuo a individuo comportano un’eterogeneità di risposta ai farmaci. Poter sviluppare terapie ad hoc per ciascun paziente apre la strada a una medicina personalizzata che tiene conto della specificità dell’individuo.
Il laboratorio BioEra adotta un approccio interdisciplinare che unisce l’ingegneria alla biologia per applicazioni biomediche e non è un caso se i primi due autori dello studio pubblicato su Nature Methods sono Camilla Luni, ingegnere, e Stefano Giulitti, biotecnologo.
Il lavoro è stato possibile grazie al contributo della Fondazione Cassa di Risparmio di Padova e Rovigo nell’ambito dei “Progetti di Eccellenza”, e ai finanziamenti dell’università di Padova (progetto strategico TRANSAC e Progetto Giovani Studiosi 2010).









